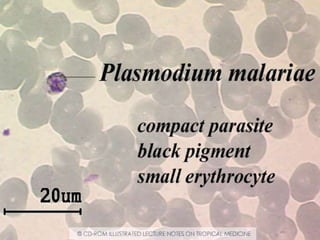

The document provides a historical overview of malaria. Some key points:
- Malaria symptoms have been described as early as 2700 BC in China and 400 BC by Hippocratic writings.
- In 1880, Charles Louis Alphonse Laveran discovered the malaria parasite in blood samples.
- In 1897, Ronald Ross demonstrated that malaria can be transmitted from infected patients to mosquitoes.
- In 1898, it was shown that the human malaria parasites Plasmodium falciparum, P. vivax, and P. malariae complete their life cycle within mosquitoes.
- Major developments in the 20th century included the 1955 WHO malaria eradication program using DDT and